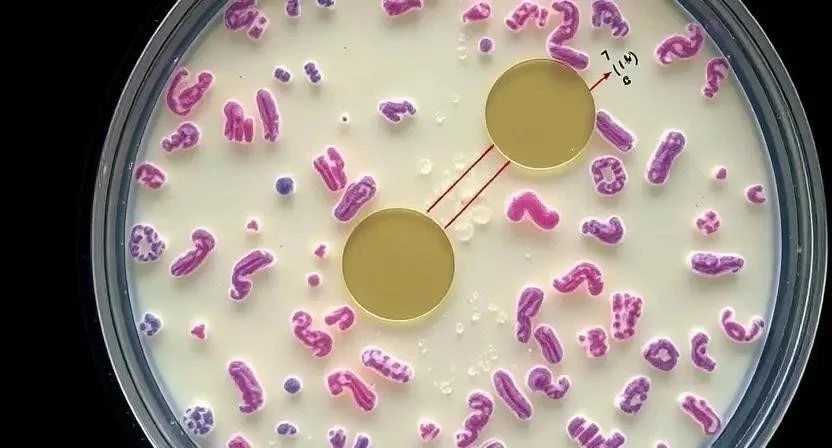

Возникает вопрос, как быстро и точно определить причину недомогания, если подозреваешь бактериальную инфекцию? Современная медицина располагает широким арсеналом методов, среди которых особое место занимают иммунологические исследования. Они позволяют не только выявить наличие инфекции, но и оценить состояние иммунной системы пациента. По статистике, своевременная и точная диагностика бактериальных инфекций повышает эффективность лечения в 2-3 раза. Ключевое слово – бактериальные инфекции. Именно поэтому важно понимать, какие методы существуют и как они работают.
- Что такое иммунологические исследования
- Методы диагностики бактериальных инфекций
- Изучение антител и антигенов
- Диагностика конкретных бактерий
- Иммунологические исследования и коллективный иммунитет
- Преимущества иммунологических методов
- Типичные ошибки и ограничения
- FAQ
- Таблица 1: Сравнение методов диагностики бактериальных инфекций
- Таблица 2: Интерпретация результатов иммунологических тестов
- Таблица 3: Особенности диагностики различных бактерий
Что такое иммунологические исследования
Иммунологические исследования – это комплекс анализов, направленных на изучение иммунной системы организма и ее реакции на различные патогены, в том числе бактерии. В основе этих исследований лежит взаимодействие антигенов (веществ, вызывающих иммунный ответ) и антител (белков, вырабатываемых иммунной системой для борьбы с антигенами). Принципы работы иммунологических методов основаны на выявлении и количественной оценке этих комплексов. Основные методы включают иммунофлюоресценцию, серологию и иммуногистохимию. Иммунофлюоресценция использует флуоресцентные метки для визуализации антигенов и антител в образце. Серология исследует сыворотку крови на наличие антител к определенным бактериям. Иммуногистохимия применяется для выявления антигенов в тканях.
Методы диагностики бактериальных инфекций
Существует несколько основных методов диагностики бактериальных инфекций. Бактериологический посев – это классический метод, который позволяет выделить и идентифицировать бактерии из биологического материала. ПЦР-диагностика (полимеразная цепная реакция) – это молекулярно-биологический метод, который позволяет обнаружить ДНК бактерий даже в небольших количествах. Иммунологические методы, такие как иммунофлюоресценция и серология, позволяют выявить антигены и антитела, связанные с бактериальной инфекцией. Сравнение этих методов показывает, что бактериологический посев является наиболее трудоемким и длительным, но позволяет получить информацию о чувствительности бактерий к антибиотикам. ПЦР-диагностика отличается высокой чувствительностью и скоростью, но не дает информации о чувствительности к антибиотикам. Иммунологические методы позволяют быстро оценить состояние иммунной системы, но могут давать ложноположительные результаты при наличии перекрестных реакций.

Изучение антител и антигенов
Антитела и антигены играют ключевую роль в диагностике бактериальных инфекций. Антигены – это молекулы, которые распознаются иммунной системой как чужеродные. Антитела – это белки, которые вырабатываются иммунной системой в ответ на антигены. Количественные показатели антител (титр) позволяют оценить интенсивность иммунного ответа. Интерпретация результатов требует учета стадии инфекции. На ранних стадиях инфекции преобладают антигены, а затем повышается уровень антител. Уровень антител может оставаться повышенным в течение длительного времени после выздоровления, что свидетельствует о формировании иммунитета. Я помню, как однажды, при подозрении на стрептококковую инфекцию, анализ на антитела помог мне быстро начать лечение и избежать осложнений.
Диагностика конкретных бактерий
Диагностика различных бактерий имеет свои особенности. Стафилококк требует посева на специальные питательные среды и определения чувствительности к антибиотикам. Стрептококк диагностируется с помощью экспресс-теста на стрептококковый антиген и посева на кровяной агар. Энтерококк требует посева на специальные среды и определения резистентности к антибиотикам. Хламидии диагностируются с помощью ПЦР-диагностики и иммунофлюоресцентного анализа. В моей практике был случай, когда диагностика хламидийной инфекции была затруднена из-за низкой концентрации бактерий, но ПЦР-диагностика позволила получить точный результат. Важно помнить, что для каждого возбудителя существуют свои специфические методы диагностики.
Иммунологические исследования и коллективный иммунитет
Иммунологические исследования играют важную роль в оценке эффективности вакцинации и изучении распространения инфекций. Оценка уровня антител к определенным бактериям позволяет определить процент людей, имеющих иммунитет к этой инфекции. Это позволяет оценить уровень коллективного иммунитета и прогнозировать риск эпидемий. Изучение распространения инфекций с помощью иммунологических методов позволяет выявить очаги инфекции и разработать эффективные меры профилактики. Я считаю, что вакцинация – это один из самых эффективных способов защиты от бактериальных инфекций, и иммунологические исследования помогают нам контролировать эффективность вакцинации.
Преимущества иммунологических методов
Иммунологические методы обладают рядом преимуществ. Высокая чувствительность позволяет выявлять инфекцию на ранних стадиях. Специфичность обеспечивает точную диагностику. Скорость получения результатов позволяет быстро начать лечение. Кроме того, иммунологические методы позволяют оценить состояние иммунной системы пациента и подобрать оптимальную терапию. В отличие от бактериологического посева, иммунологические методы не требуют длительного культивирования бактерий. В моей лаборатории мы всегда стараемся использовать иммунологические методы для быстрой и точной диагностики бактериальных инфекций.
Типичные ошибки и ограничения
Несмотря на свои преимущества, иммунологические методы имеют свои ограничения. Факторы, влияющие на точность результатов, включают качество образца, используемые реагенты и квалификацию персонала. Интерпретация ложноположительных и ложноотрицательных результатов требует опыта и знаний. Ложноположительные результаты могут возникать при наличии перекрестных реакций или аутоиммунных заболеваний. Ложноотрицательные результаты могут возникать при подавлении иммунной системы или на ранних стадиях инфекции. Однажды я столкнулся с ложноотрицательным результатом при диагностике стрептококковой инфекции у пациента с иммунодефицитом.
FAQ
Вопрос: Что такое иммунофлюоресцентный анализ?
Ответ: Иммунофлюоресцентный анализ – это метод, который использует флуоресцентные метки для визуализации антигенов и антител в образце.
Вопрос: Что такое серологический тест?
Ответ: Серологический тест – это анализ крови, который позволяет выявить антитела к определенным бактериям.
Вопрос: Как подготовиться к иммунологическому исследованию?
Ответ: Обычно требуется сдать кровь натощак. Перед исследованием необходимо проконсультироваться с врачом.
Вопрос: Как долго ждать результатов иммунологического исследования?
Ответ: Срок получения результатов зависит от метода исследования и лаборатории. Обычно результаты готовы в течение нескольких дней.
Вопрос: Что делать, если результат иммунологического исследования оказался положительным?
Ответ: Необходимо обратиться к врачу для назначения лечения.
Таблица 1: Сравнение методов диагностики бактериальных инфекций
| Метод | Чувствительность | Специфичность | Скорость | Стоимость |
|---|---|---|---|---|
| Бактериологический посев | Средняя | Высокая | Длительная | Низкая |
| ПЦР-диагностика | Высокая | Высокая | Быстрая | Средняя |
| Иммунофлюоресценция | Высокая | Средняя | Быстрая | Средняя |
| Серология | Средняя | Средняя | Быстрая | Низкая |
Таблица 2: Интерпретация результатов иммунологических тестов
| Тест | Результат | Интерпретация |
|---|---|---|
| Иммунофлюоресценция | Положительный | Наличие антигена или антитела |
| Иммунофлюоресценция | Отрицательный | Отсутствие антигена или антитела |
| Серология | Высокий титр антител | Активная инфекция или перенесенная инфекция |
| Серология | Низкий титр антител | Отсутствие инфекции или ранние стадии инфекции |
Таблица 3: Особенности диагностики различных бактерий
| Бактерия | Метод диагностики | Особенности |
|---|---|---|
| Стафилококк | Посев, ПЦР | Определение чувствительности к антибиотикам |
| Стрептококк | Экспресс-тест, посев | Быстрая диагностика |
| Энтерококк | Посев | Определение резистентности к антибиотикам |
| Хламидии | ПЦР, иммунофлюоресценция | Высокая чувствительность |







